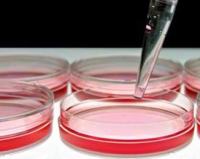
细胞活力检测

原代/传代细胞培养
- 询价
- 2025年07月16日
- 详细信息
- 文献和实验
- 技术资料
背景知识:
细胞培养技术也叫细胞克隆技术,在生物学中的正规名词为细胞培养技术。不论对于整个生物工程,还是其中之一的生物克隆技术来说,细胞培养都是一个必不可少的过程,细胞培养本身就是细胞的大规模克隆。因为生物产品都是从细胞得来,所以可以说细胞培养技术是生物技术中最核心、最基础的技术。
技术原理:
细胞培养就是模拟体内的生理环境,在适当的条件下,使活体组织细胞在体外环境存活,生长增殖,并维持其结构和功能。细胞的生长需要营养环境,用于维持细胞生长的营养基质称为培养基。培养基按其物理状态可分为液体培养基和固体培养基。从多细胞生物中分离所需要细胞和扩增获得的细胞以及对细胞进行体外改造,观察,必须解决细胞离体培养问题,同微生物细胞培养的难易相比,比较困难的是来自多细胞生物的单细胞培养,特别是动物细胞的培养。
重要意义:
⒈可以进行体外受精及胚胎发育过程研究。
⒉可以进行生长发育有关的重要基因或影响因素的研究。
⒊可以方便地通过实验手段培育新品种。
风险提示:丁香通仅作为第三方平台,为商家信息发布提供平台空间。用户咨询产品时请注意保护个人信息及财产安全,合理判断,谨慎选购商品,商家和用户对交易行为负责。对于医疗器械类产品,请先查证核实企业经营资质和医疗器械产品注册证情况。
文献和实验类型细胞也可以考虑加一些特殊的生长因子,如胰岛素能促使细胞摄取葡萄糖和氨基酸。另外,内毒素、EGF、FGF等均有促有丝分裂作用,但费用较高。 二、传代培养及其操作步骤 原代细胞培养成功以后,需要进行分离培养,否则细胞会因生存空间不足或密度过大,营养障碍,影响细胞生长。细胞由原培养瓶内分离稀释后传到新的培养瓶中培养的过程称之为传代培养。传代细胞允许培养的细胞扩增(形成细胞株),可以进行细胞克隆,易于保存,但可能丧失一些特殊的细胞和分化特征。传代细胞形成细胞株的最大利处在于提供了大量持久的实验
什么是传代细胞培养?原代细胞或细胞株或细胞系需在体外持续地培养就必须传代,以便获得稳定的原代细胞或细胞株或细胞系或得到大量的同种细胞,并维持细胞种的延续,这个过程体外培养称为传代细胞培养。一般认为,细胞培养形成单层汇合,细胞密度与生存空间有密切的关系,将培养细胞分散,以1:2或l:3或1:4以上的比率转移分散进行培养,即为传代细胞培养。细胞传代后,一般经过三个阶段:游离期、指数增生期和停止期。常用细胞分裂指数表示细胞增殖的旺盛程度,即细胞群的分裂相数/100个细胞。一般细胞分裂指数介于0.2%
细胞系与培养条件:细胞系来自于ATCC。按照 ATCC 的建议进行HeLa(#CCL-2)、U2OS (#HTB-96)、SH-SY5Y(#CRL-2266)、CHO-K1 (#CCL-61)、人血管内皮细胞(HUVEC;# PCS-100-010 批号 58570370)与混合肾原代上皮细胞(MREC;ATCC # PCS-400-012 lot # 58488854)的培养,肿瘤细胞系传代至 10 代以上,原代细胞系传代至 4 代。 检测程序:所有检测均于组织培养器(5% CO2,37
技术资料暂无技术资料 索取技术资料